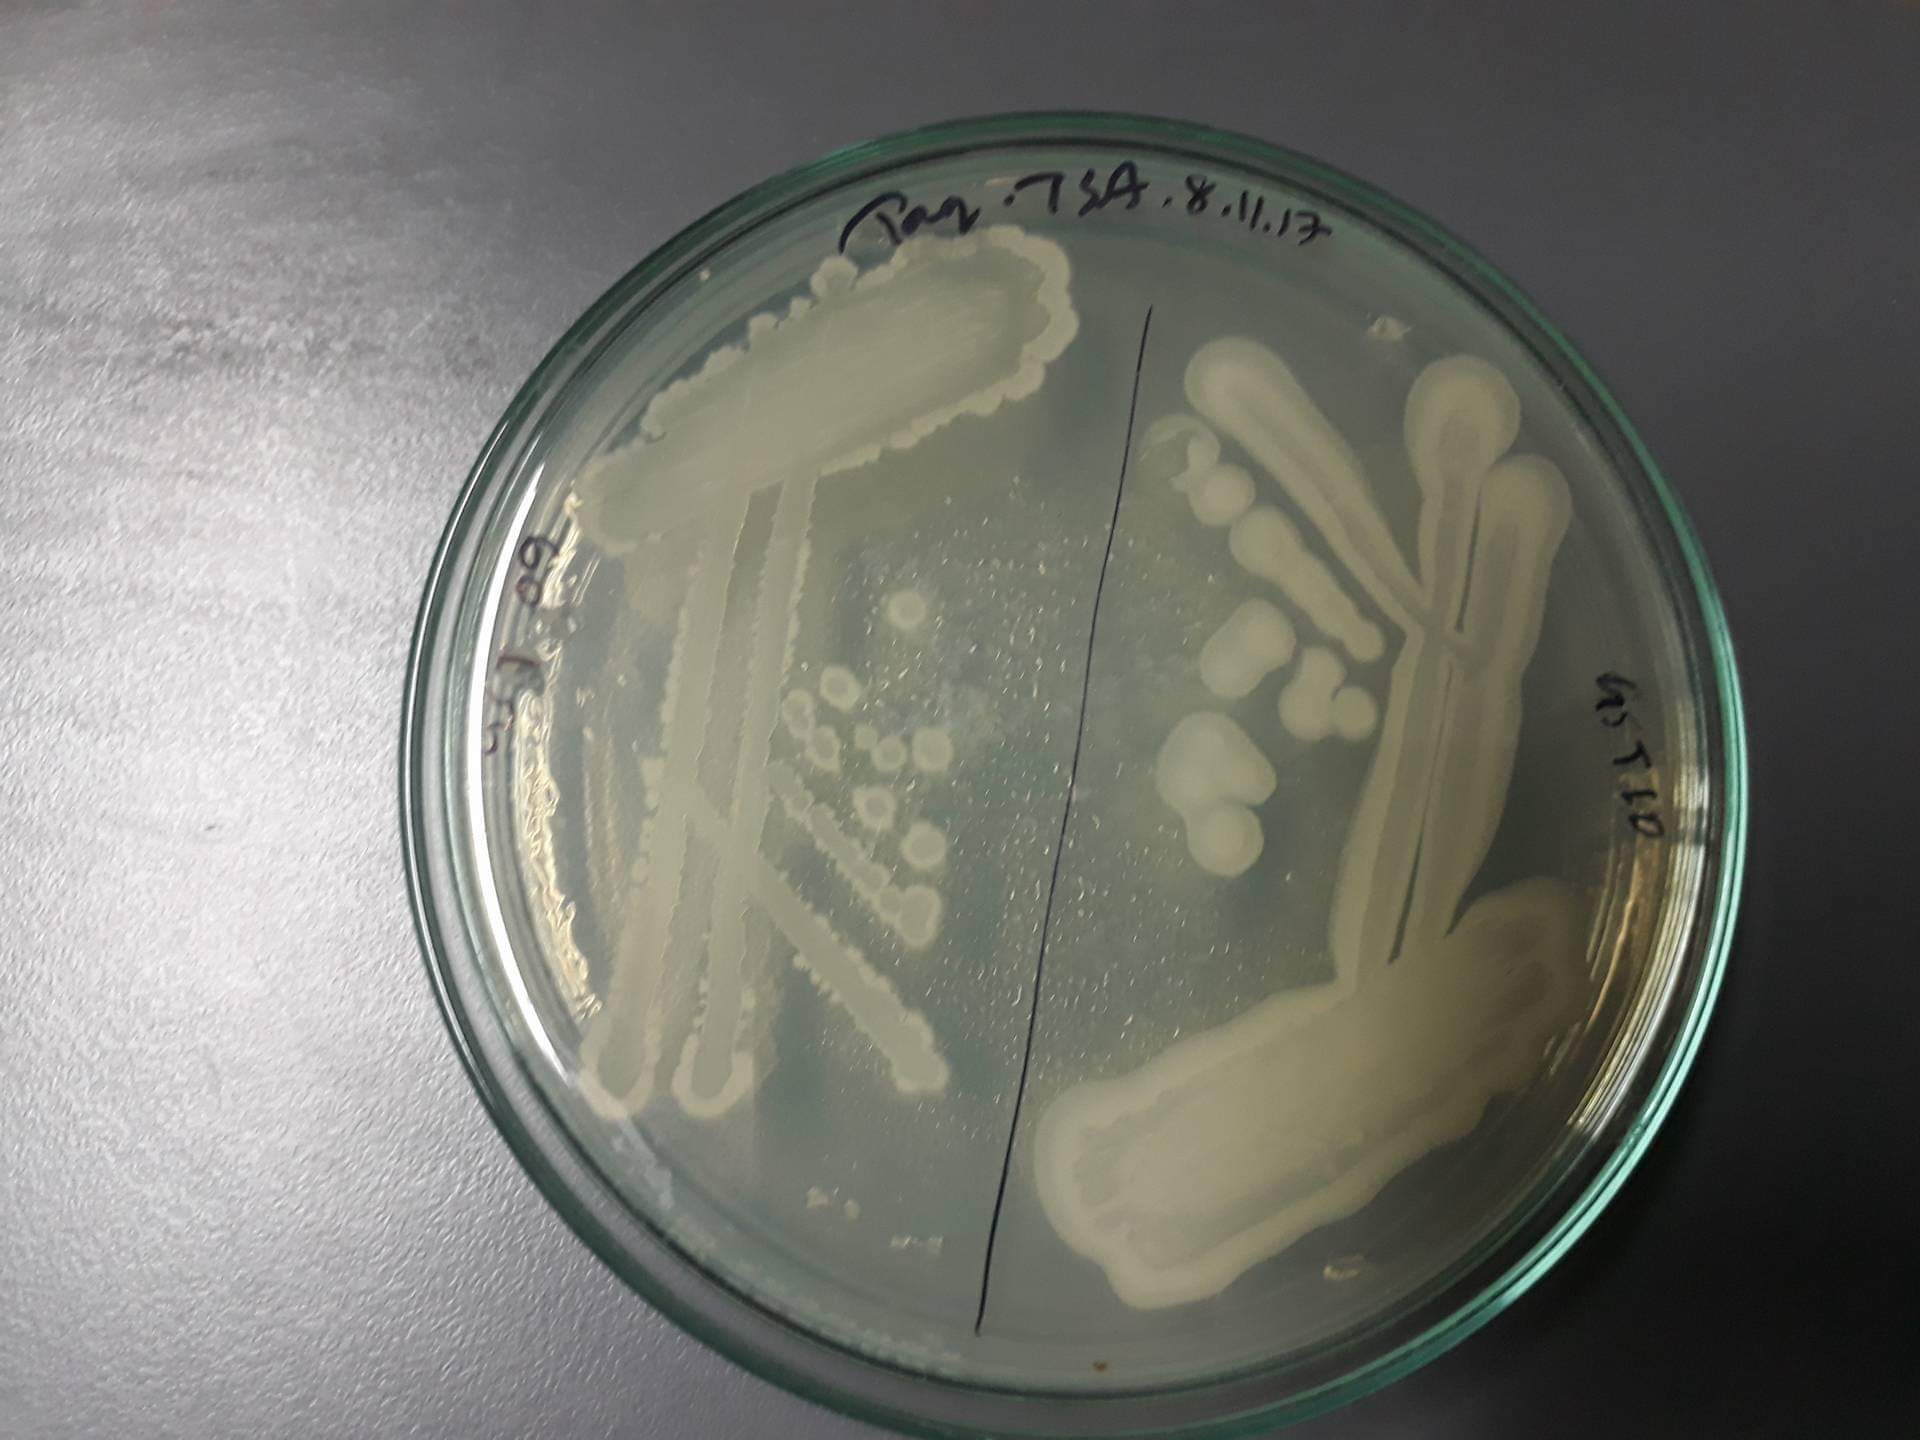
Gentamicin sulfate 6442

Gentamicin sulfate
Tocris Bioscience | Catalog # 6442
Aminoglycoside antibiotic


Loading...
Product Description
Gentamicin sulfate is an aminoglycoside antibiotic. Irreversibly binds bacterial ribosomes and disrupts protein synthesis. Active against gram-positive and -negative bacteria. Stable over wide range of temperatures. Gentamicin sulfate can be used in a small molecule cocktail to generate 3D culture of lung alveolar cells (see below protocol).For more information about how Gentamicin sulfate may be used, see our protocol: 3D Culture of Lung Alveolar Cells
Product Specifications for Gentamicin sulfate
Storage
Store at +4°C
CAS Number
1405-41-0
PubChem ID
44134731
InChI Key
RDEIXVOBVLKYNT-UHFFFAOYSA-N
SMILES
CC(C1CCC(C(O1)OC2C(CC(C(C2O)OC3C(C(C(CO3)(C)O)NC)O)N)N)N)N.CC(C1CCC(C(O1)OC2C(CC(C(C2O)OC3C(C(C(CO3)(C)O)NC)O)N)N)N)NC.CC1(COC(C(C1NC)O)OC2C(CC(C(C2O)OC3C(CCC(O3)CN)N)N)N)O.OS(=O)(=O)O
The technical data provided above is for guidance only. For batch specific data refer to the Certificate of Analysis.
Loading...
Solubility
| Solubility | Soluble to 100mg/ml in water |
Calculators
Background References
References are publications that support the biological activity of the product.
- Schroeder Modulation of RNA function by aminoglycoside antibiotics. EMBO.J. 2000 PMID: 10619838
- Casemore Gentamicin as a bactericidal agent in virological tissue cultures. J.Clin.Pathol. 1967 PMID: 4972293
Product Documents for Gentamicin sulfate
Certificate of Analysis
To download a Certificate of Analysis, please enter a lot or batch number in the search box below.
Product Specific Notices for Gentamicin sulfate
For research use only
Citations for Gentamicin sulfate
Customer Reviews for Gentamicin sulfate (1)
5 out of 5
1 Customer Rating
Have you used Gentamicin sulfate?
Submit a review and receive an Amazon gift card!
$25/€18/£15/$25CAN/¥2500 Yen for a review with an image
$10/€7/£6/$10CAN/¥1110 Yen for a review without an image
Submit a review
Customer Images
Showing
1
-
1 of
1 review
Showing All
Filter By:
-
Species: E.coliAssay Type: In VitroVerified Customer | Posted 11/05/2018AgNP suspension of 100 ppm was prepared by dissolving 0.1 mg of AgNPs in 1 mL autoclaved deionized water.Combination of Gentamycin with silver nanoparticles was studied to identify how antibacterial properties differ against E.coli. Different strains of Gentamycin resistant E.coli was also used.
There are no reviews that match your criteria.
Loading...